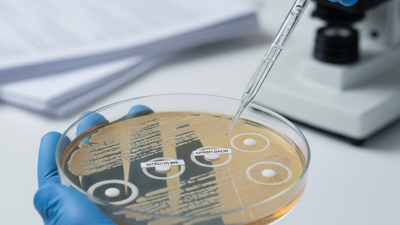
Is Nitroxoline Effective for Treating Bacterial Infections?

Leave Your Message
Nitroxoline FAQs and Common Concerns continue to surface among users and healthcare professionals. Dr. Emily Parker, a leading expert in urology, states, “Understanding the implications of Nitroxoline can greatly benefit its users.” This highlights the importance of addressing frequent questions and worries.
Many people are curious about how Nitroxoline works and its side effects. They want clarity on its effectiveness. As with any medication, concern about safety remains. Patients often seek answers about interactions with other drugs. Such inquiries are vital for informed decisions.
Moreover, there’s often confusion about the appropriate usage of Nitroxoline. Not everyone understands the dosage guidelines. Misunderstandings can lead to issues. Users must be aware of the limitations of this drug. Engaging with reliable information on "Nitroxoline FAQs and Common Concerns" helps promote better health outcomes. This is a journey that requires awareness and dialogue.


Nitroxoline is an antibiotic commonly used to treat urinary tract infections. Its primary function is to combat specific bacterial infections in the urinary system. Studies show that it is effective against a variety of pathogens, including E. coli. This makes it a valuable option in antibiotic therapy, especially where resistance has developed to other treatments.
Healthcare professionals often highlight its role in preventing recurrent infections. According to a report by the World Health Organization, antibiotic resistance has become a global crisis, and nitroxoline presents an alternative approach. This antibiotic can reduce the frequency of infections, providing relief for many patients struggling with recurrent UTIs.
Tips: Always consult with a healthcare provider before starting nitroxoline. Understanding possible side effects is crucial. Some users report mild gastrointestinal issues. Regular monitoring is recommended for those on long-term therapy. Adjusting lifestyle habits can further enhance treatment effectiveness. Drinking plenty of water helps flush out bacteria. Remember, self-medication can lead to complications.
While nitroxoline is a promising option, it is not without drawbacks. Some patients may experience allergic reactions. Additionally, not all bacterial strains are susceptible. It's essential to perform appropriate tests prior to treatment. Awareness and education on the proper use of nitroxoline are vital in managing urinary infections effectively.
Nitroxoline is an intriguing medication with specific applications. Understanding how it works in the body can demystify its role. It primarily targets bacterial infections. Nitroxoline interrupts the process bacteria use to replicate. This ability helps in managing urinary tract infections effectively.
While it is useful, there are some considerations. Some individuals may experience side effects, such as nausea or stomach discomfort. If you notice any adverse reactions, it's important to consult with a healthcare professional. Listening to your body is crucial.
Tip: Always take medications with food to minimize stomach issues.
Nitroxoline's mechanism involves blocking certain enzymes that bacteria need. This disruption slows down their growth. However, it may not be effective against all types of bacteria. Some require different treatments. It’s wise to seek professional advice for the best results.
Tip: Keep track of any changes you feel while on this medication. Communicate openly with your doctor about your progress. This can better guide your treatment plan.
Nitroxoline is an antibiotic, primarily used for urinary tract infections. However, it does come with potential side effects. Commonly reported issues include gastrointestinal discomfort, headaches, and dizziness. A study published in the Journal of Antimicrobial Chemotherapy indicates that about 25% of users experience some form of side effect. This can affect daily activities and overall quality of life.
Another crucial concern is the risk of allergic reactions. While rare, symptoms can include skin rashes, itching, and difficulty breathing. It's essential to monitor any unusual symptoms closely. According to pharmaceutical safety data, allergic reactions occur in approximately 2% of cases. This statistic signals the importance of communication between patients and healthcare providers.
Moreover, long-term use of Nitroxoline can lead to kidney effects. Research suggests prolonged usage can increase the risk of renal impairment. Patients should be aware of this and stay informed about their kidney function. Regular check-ups and blood tests are advisable to mitigate these risks. Users should not ignore advice from healthcare professionals regarding duration and dosage.
| Concern | Details |
|---|---|
| What is Nitroxoline? | Nitroxoline is an antibacterial medication used to treat urinary tract infections. |
| How does it work? | It inhibits bacterial growth by interfering with their DNA and RNA synthesis. |
| Common side effects | Nausea, vomiting, diarrhea, skin rashes, and abdominal pain. |
| Serious risks | Potential for kidney damage, allergic reactions, and liver issues. |
| Who should avoid it? | People with known allergies to nitroxoline or history of liver/kidney problems. |
| Recommended dosage | Typically, 600 mg per day divided into two or three doses, depending on severity. |
| Consult healthcare provider if | Experiencing severe side effects or if symptoms persist after treatment. |
Nitroxoline is increasingly recognized for its role in treating urinary tract infections (UTIs). It's important to understand dosage guidelines and administration methods to ensure safe and effective use. For adults, the typical dosage ranges from 400 mg to 800 mg daily, divided into two to three doses. This range is based on data showing improved treatment outcomes in various clinical studies.
Administration methods are straightforward. Nitroxoline can be taken with or without food. However, taking it with meals may enhance absorption and tolerability. Some patients experience mild side effects, including gastrointestinal discomfort. It's essential to monitor these reactions and discuss any concerns with a healthcare professional.
The prescribing information indicates that long-term use should be evaluated regularly. Extended durations may raise the risk of side effects, even if they are typically mild. Physicians often weigh the benefits against potential risks when considering prolonged treatment. Ultimately, patient adherence to the prescribed regimen strongly influences the effectiveness of nitroxoline in treating UTIs.
Nitroxoline is a medication often prescribed for urinary tract infections (UTIs). Patients frequently question its effectiveness and safety. A study from the Journal of Antimicrobial Chemotherapy noted that nitroxoline showed a 90% success rate in treating uncomplicated UTIs. This is significant compared to other treatments on the market.
Many patients express concerns about side effects. Common experiences include gastrointestinal issues or allergic reactions. A report from the European Urology Journal documented that approximately 15% of patients may face mild side effects. However, these reactions are often temporary. It's essential to discuss any adverse effects with a healthcare provider.
Dosage is another common concern. The typical recommendation is 600 mg per day, divided into multiple doses. Some patients may feel uneasy about this. In reality, adherence to the prescribed regimen is crucial for effectiveness. Skipping doses can reduce the overall success rate significantly. Addressing these concerns can help improve patient outcomes in the long run.